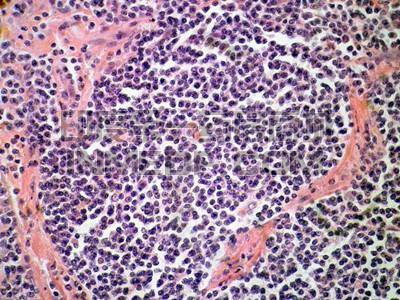
边缘区B细胞淋巴瘤

【资讯导读】 边缘区B细胞淋巴瘤(Marginal zone B-cell lymphoma,MZBL)是一种发生于边缘区的淋巴瘤,是血液系统恶性肿瘤性疾病。目前从临床上来看淋巴瘤的发病因素主要和感染、接触放射线、基因
边缘区B细胞淋巴瘤(Marginal zone B-cell lymphoma,MZBL)是一种发生于边缘区的
淋巴瘤,是血液系统恶性
肿瘤性疾病。目前从临床上来看淋巴瘤的发病因素主要和感染、接触放射线、基因缺陷、遗传等有关。
根据不同的临床表现和病理特征分为3种亚型:
①结节边缘区淋巴瘤(marginalzoneB-celllymphoma,MZBL)
②粘膜相关淋巴组织淋巴瘤(MALT),也叫结外边缘区淋巴瘤
③脾边缘区淋巴瘤(Splenic marginal zone lymphoma,SMZL)
治疗药物
1、利妥昔单抗(Rituximab)
利妥昔单抗又称美罗华,是一种分子
靶向药,临床上可用于治疗复发或耐药中央型滤泡型淋巴瘤,结合CHOP方案治疗CD20阳性的弥漫性大B细胞淋巴瘤。
2、Zevalin(ibritumomab tiuxetan)泽维宁(替伊莫单抗)
Zevalin是一种CD20分子靶向放射性抗体药物,用于治疗复发或难治性,低分化或滤泡型B细胞非霍奇金淋巴瘤(NHL)。
3、Ukoniq(umbralisib)
Ukoniq(umbralisib)用于治疗既往接受过至少一种基于抗CD20疗法的复发/难治性边缘区淋巴瘤(MZL)患者,以及既往接受过至少三线全身治疗的复发/难治性滤泡性淋巴瘤(FL)成人患者。